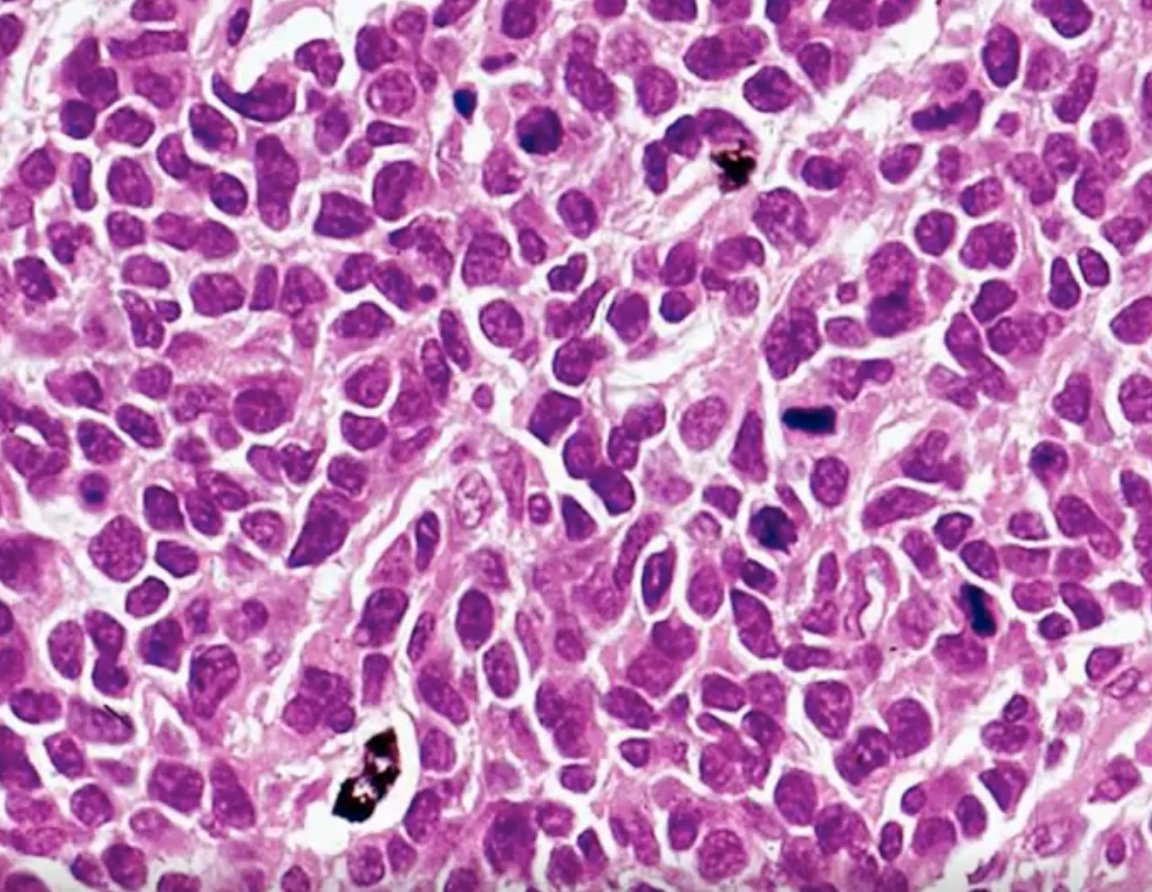
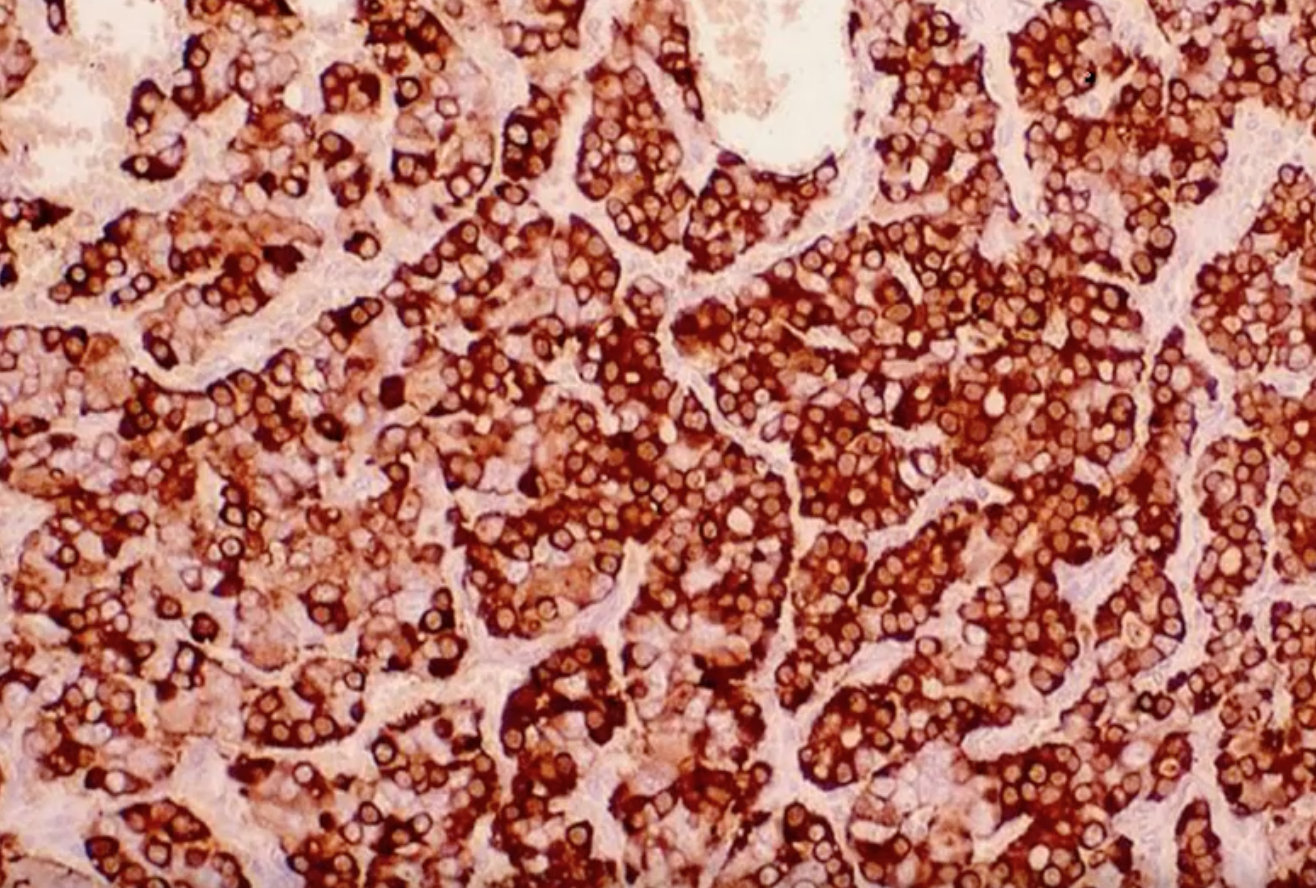

benign
lung tissue + cartilage
calcified on imaging
bronchial hamartoma
list subtypes (4) of non-small cell carcinoma
adenocardinoma
squamoud cell carcinoma
large cell neuroendocrine carcinoma
carcinoid tumour
seen in

small cell carcinoma
(lung)
mitotic activity
poorly differentiated small cells
smoking
sentral tumour (central)
syndromes - paraneoplastic (ADH, ACTH, LEMs) - lambert eaton
Tx with chemotherapy
what is a unique site of distant metastasis of primary lung carcinoma
adrenal gland
lung cancer causing horseness is likely affecting
recurrent laryngeal nerve
lung cancer at apex
ptosis
miosis
anhidrosis
pancost tumour
(apex of lung)
Horner syndrome - SNS chain involvement
affected by lung cancer
what mutations (2) may be present in adenocarcinoma of lung
EGFR
ALK translocation
common non-smoking asian females
EGFR = tyrosine kinase receptor
what lung cancer subtypes affect male smokers, are located centrally and posess paraneoplastic syndromes
SCLC
SCC (squamous)
SCLC - LEMs, ADH, ACTH
SCC - PTHrP
what group of persons is adenocarcinoma of lung most seen in
female non-smokers
EFGR mutation association - asian non-smoking females
cancer located peripherally
male
smoker
mitotic changes
necrosis
poorly differentiated small cells
chromogranin (+)
LEMs
SCLC
PNP syndrome - also ADH, ACTH
central location
male smokers
small cells
male
smoker
hypercalcaemia

SCC
(squamous cell carcinoma)
keratin pearls
intercellular bridges

central
male smoker
PNP syndrome - PTHrP
glands
mucin
nonsmoker
female
peripheral tumor
pneumonia-like consolidation

adenocarcinoma lung
lepidic pattern
columnar cells along preexisting brtonchioles/aveoli
peripheral
pneumonia-like consolidation
good prognosis

adenocarcinoma in situ = bronchioalveolar carcinoma
what lung cancer is determined by diagnosis of exclusion
large cell neuroendocrine carcinoma
smoking
central or perihpheral
well differentiated
neuroendocrine cell nests
chromogranin (+)
polyp like

carcinoid tumour
can cause carcinoid syndrome
central = polyp-like
peripheral
flushing
diarrhoea
abdominal pain
wheezing
tumour
carcinoid syndrome
serotonin secreting - can be from carcinoid tumour (rare)
Tx with so
but common on exam Q
2 causes of emphysema
smoking
a-1 antitrypsin deficiency
*
(imbalance proteases:antiproteases)*
centriacinar - smoking - UL
panacinar - a-1 AT - LL
centriacinar and panacinar emphysema affects which parts of the lung
centriacinar = UL (smoking)
panacinar = LL (a-1 AT)
cause of a1-AT deficiency
misfolding of mutated protein
ccumulates in endoplastic reticulum of hepatocytes –> liver damage
what marker is seen in a-1 AT
PAS (+)
what is the function of a-1 AT
neutralises proteases
deficiency a-1 AT = increased proteases (inflammation)
what is the PiM allele in a-1 AT
normal
(PiM or PiMM)
what allele mutation is associated with low levels of a-1 AT
PiZ
what allele mutation is associated with increased risk of emphysema with smoking
PiMZ






